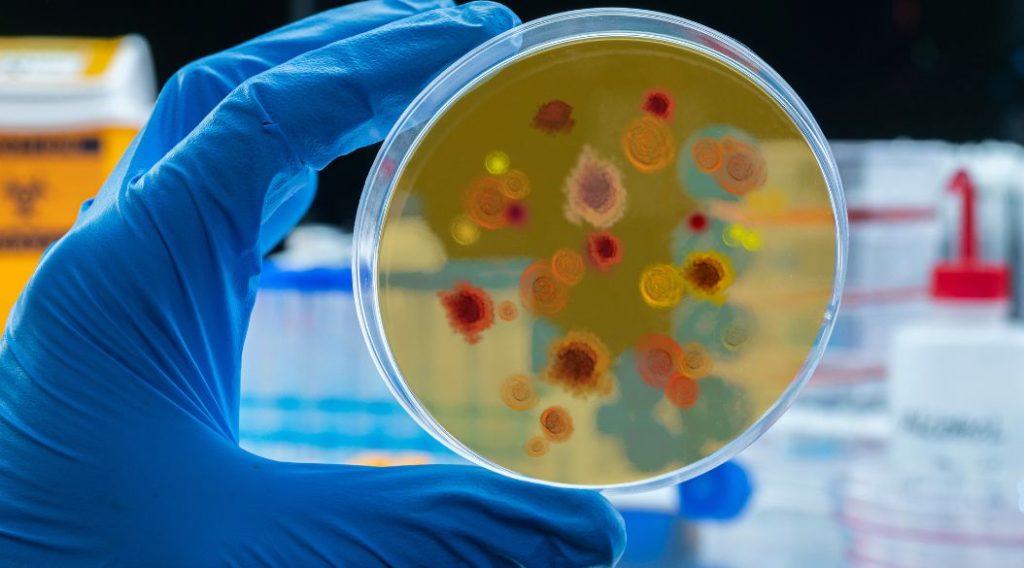
Malaria

Tercer país aprueba uso vacuna contra la malaria en niños

El Instituto e Investigaciones en Ciencias de la Salud (IRSS – Institut de Recherche en Sciences de la Santé) y la Universidad de Oxford han anunciado que la agencia reguladora de medicamentos de Burkina Faso (ANRP – Agence Nationale de la Regulation Pharmaceutique) ha aprobado el uso de la vacuna contra la malaria R21/Matrix-M™ en […]
Inician ensayo clínico de fase 1 en vacuna contra malaria

BioNTech, la empresa biotecnológica alemana conocida por su trabajo en el desarrollo de la vacuna COVID-19, ha anunciado el inicio de un estudio de fase 1 en humanos con BNT165b1, el primer candidato de su vacuna contra la malaria con la tecnología ARNm mensajero. La tecnología de ARNm mensajero utilizada por BioNTech permite que la […]
OPS capacita a personal médico en el tratamiento de la malaria grave
Desde finales de abril un equipo especializado de la Organización Panamericana de la Salud (OPS) visita establecimientos médicos en diez municipios del estado Bolívar para capacitar a su personal en el diagnóstico y tratamiento de la malaria grave. A la fecha se han capacitado 334 profesionales de la salud de 19 establecimientos de alta complejidad. […]
Dengue continúa en aumento, reportan 35 casos la última semana

SANTO DOMINGO.- El aumento de enfermedades transmitidas por vectores continúa constante en el país, desde la semana epidemiológica 28 a la 29 se han registrado 35 probables casos de dengue, para un total de 810 casos, incluidos 11 fallecimientos. De acuerdo al Boletín Epidemiológico Semanal número 29, emitido por la Dirección Nacional de Epidemiología en […]
Desarrollan primera vacuna contra malaria que muestra 77 % de eficacia en un ensayo fase IIb

Una nueva vacuna contra la malaria ha demostrado ser altamente eficaz en los primeros ensayos en África y podría suponer un gran avance contra la enfermedad. Científicos del Instituto Jenner de la Universidad de Oxford (Reino Unido) desarrollaron la vacuna, que mostró una eficacia de hasta el 77 % durante 12 meses de seguimiento en […]
El Salvador se convierte en el primer país de Centroamérica en erradicar la malaria

El Salvador se ha convertido en el primer país de Centroamérica en erradicar la malaria, según ha anunciado el director del programa global contra la malaria de la Organización Mundial de la Salud(OMS), Pedro Alonso. «Reconocimiento histórico de eliminación de malaria. Confiando pronta certificación por OMS. Primer país de Centroamérica en lograr este hito», ha […]